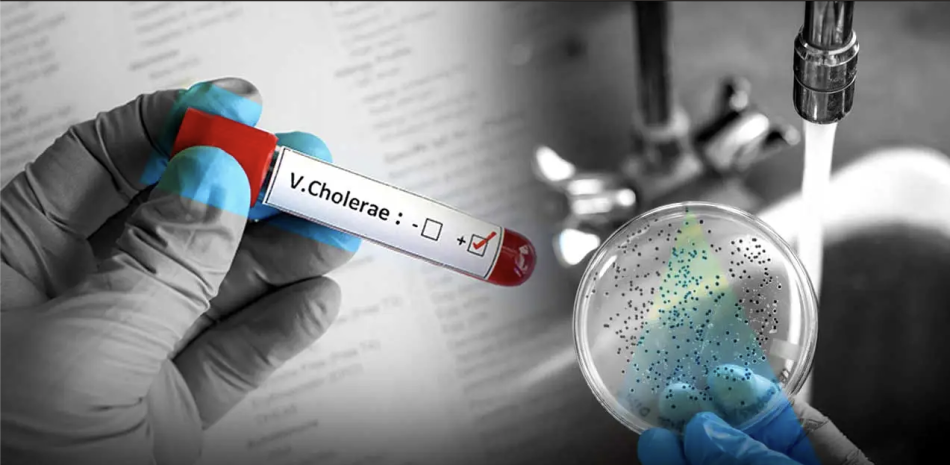

Autoridades registraron tres casos sospechosos de cólera en el país, tras brote en Haití; mantienen vigilancia en provincias fronterizas.
En la última semana que va del año, el país reportó tres casos sospechosos de cólera, sin casos confirmados, ni muertes hasta el momento, según el Ministerio de Salud Pública (MSP).
En el boletín epidemiológico correspondiente a la semana 44, las autoridades sanitarias señalaron que permanece un “riesgo elevado” para el territorio nacional debido al brote de casos que Haití continúa reportando.
“Haití continúa reportando brotes comunitarios de cólera con circulación confirmada de Vibrio cholerae O1, lo que mantiene la posibilidad de introducción de casos importados por vía terrestre y fluvial”, informaron.
Hasta la fecha, se reportó un acumulado de 30 casos sospechosos de esta infección bacteriana intestinal.
La concentración de casos se reportó en Santo Domingo, con nueve casos; Santiago, seis; Distrito Nacional, dos; Barahona, dos; y Monte Cristi, dos.
Salud Pública informó que mantiene bajo vigilancia a provincias fronterizas como Dajabón, Elías Piña, Independencia y Pedernales, debido al riesgo de propagación de casos desde Haití.
plan nacional de contingencia
Ante la amenaza sanitaria, Salud Pública informó que mantiene activo el Plan Nacional de Contingencia para la prevención y control del cólera para fortalecer la capacidad de respuesta del país.
El plan incluye la vigilancia activa de diarreas agudas, el tamizaje en puntos fronterizos y mercados binacionales, la toma de muestras de agua y alimentos, la distribución de sales de rehidratación oral, cloro y kits de emergencia, así como la educación sanitaria sobre higiene, lavado de manos y uso seguro del agua.
síntomas
Las autoridades sanitarias definen al cólera como una infección bacteriana intestinal causada por el bacilo Vibrio cholerae, que se transmite principalmente a través de agua o alimentos contaminados.
Los síntomas son diarrea acuosa y severa y vómitos, que, en caso de no tratarse, puede conllevar la deshidratación y, en casos extremos, la muerte.
Ante la presencia de estos síntomas, se recomienda acudir de inmediato al centro de salud más cercano. Se recuerda que no toda diarrea o molestia estomacal es señal de cólera, ya que existen diversos patógenos que causan enfermedades diarreicas agudas.
Los riesgos aumentan en áreas con saneamiento deficiente, agua no segura e higiene inadecuada.
Para prevención se recomienda el lavado adecuado de manos, consumir alimentos y agua potable segura, además de mantener unas óptimas condiciones sanitarias.
En caso de no contar con agua potable, se debe hervir o colocar cinco gotas de cloro por galón, antes de consumirla o usarla para cocinar.
El 23 de octubre, Listín Diario registró que ante los casos de cólera en Haití, la Dirección Provincial de Salud Pública había implementado un protocolo sanitario en el puente fronterizo que une Juana Méndez y Dajabón como medida de prevención.
Se informó que la directora de Salud en Dajabón, Saberkis Rodríguez, había realizado un recorrido de supervisión por el paso fronterizo para que se apliquen los protocolos que tengan que ver con salud.
“Pueden ver los inspectores de salud aquí en el puente, donde no permiten la entrada de alimentos cocinados desde Haití hacia República Dominicana debido a que no tenemos el control de las condiciones que esos alimentos son preparados”, dijo entonces la directora de Salud en Dajabón.
la crisis en haití
De acuerdo a la agencia EFE, el 22 de octubre se registró que Haití enfrentaba un nuevo brote de cólera, con 17 muertes confirmadas desde la segunda semana de septiembre, que podrían aumentar por la falta de condiciones sanitarias y las lluvias que se esperaban durante esos días en un contexto de extrema vulnerabilidad con 1.4 millones de desplazados internos a causa de la violencia que imponen las sangrientas bandas armadas.
Sin embargo, las autoridades sanitarias de República Dominicana asguraban el control para evitar casos.
Repunte de los casos de cólera
En Haití.
Según la agencia EFE, el 22 de octubre varios municipios del departamento del Oeste, entre ellos Pétion-Ville, situado en la parte alta de Puerto Príncipe, estaban desde septiembre a un repunte de casos de cólera, que habían disminuido en los dos últimos años, tras el brote declarado en octubre de 2022.https://listindiario.com/la-republica/sector-salud/20251115/salud-reporta-tres-casos-sospechosos-colera_882368.html